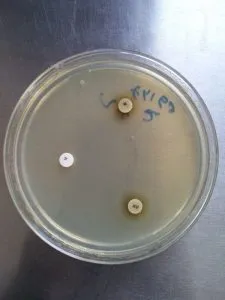
X and V Factor: Growth is seen around XV Factor only. - X and V Factor: Growth is seen around XV Factor only.

Most Haemophilus species are normal inhabitants of upper respiratory tract of humans and other animals. The species of Haemophilus that most frequently cause human infections are H. influenzae (respiratory and invasive infections), H. aegyptius (acute conjunctivitis), H. parainfluenzae, H. haemolyticus, H. parahaemolyticus, H. aprophilus, H. paraphrophilus and H. segnis (abscesses and infective endocarditis).
- These are pleomorphic Gram-negative coccobacilli.
- The laboratory diagnosis of H. influenzae is based on growth and colony morphology in chocolate agar, and cell morphology on Gram staining.
- These are confirmed by the haemophilic character of the genus that reflects a requirement for either or both of the two factors called X and V. The X factor comprises haemin or other iron-containing porphyrins and the V factor comprises nicotinamide adenine dinucleotide (NAD).
Disease
Haemophilus influenzae can cause many kinds of infections. Which can range from mild ear infections to severe diseases, like meningitis. Haemophilus influenzae bacteria most often cause pneumonia, bacteremia, and meningitis mostly in infants and children younger than five years of age.
| Disease | Species | Specimen for culture |
|---|---|---|
| Meningitis | H. influenzae type b | Cerebrospinal fluid (CSF); blood |
| Epiglottis | H. influenzae type b | Blood; laryngeal secretions |
| Otitis media | H. influenzae nontypeable strains | Swab of drainage in ear canal; needle aspiration. If systemic disease is suspected blood/CSF culture is recommended |
| Acute sinusitis | H. influenzae usually nontypeable strains; in rare cases H. parainfluenzae is also involved | Sinus aspirates, surgical specimens |
| Acute Pharyngitis/ laryngotracheobronchitis | H. influenzae type b | Posterior pharyngeal swab; laryngeal secretions |
| Bronchitis | H. influenzae nontypeable strains | Sputum; transtracheal aspirates; bronchial washings |
| Pneumonia | H. influenzae type b; incase of elderly patients nontypeable strains may involve | Sputum; tracheal aspirates; bronchial washings |
| Endocarditis | H. aphrophilus; H. paraphrophilus; H. parainfluenzae; rarely, H. influenza | Blood |
| Genital tract infection and postpartum bacteremia | H. influenza nontypeable; H. parainfluenzae | Urethral and endocervical specimens; blood. |
| Conjunctivitis | H. influenza biogroup aegyptius | Conjunctival swab |
| Chancroid | H. ducreyi | Swab obtained from genital ulcers; aspirates from buboes; endocervical swabs |
| Brazilian purpuric fever | H. influenzae biogroup aegyptius | Blood; conjunctival swabs; skin lesions |
Note: In spite of its name, Haemophilus influenzae does not cause influenza (the “flu”)
There are six identifiable types of Haemophilus influenzae bacteria (a through f) and other non-identifiable types (called nontypeable). Haemophilus influenzae type b, or Hib is associated with most of the clinical cases for which vaccine is also available.
Sample
Specimens used for the laboratory diagnosis of Haemophilus influenzae may be
- Specimens from respiratory tract: Sputum, lung aspirate, pleural fluid
- Body fluids e.g., Blood/ cerebrospinal fluid
- Exudates from the joint, middle ear, other sites
Sample Collection
- **Sputum:**Collect > 1.0 ml expectorated sputum in a sterile screw-capped container.
- Lung aspirate/ pleural fluidCollect > 1.0 ml by percutaneous needle aspiration in a sterile screw-capped tube.
- **Blood:**Clean the venipuncture site with 70% alcohol and iodine, allow it to evaporate and collect blood aseptically in a culture broth with an anticoagulant. In the case of adults, collect 5-10 ml of blood in culture bottle, for children < 12-year old, collect 1.5-2.0 ml of blood. Mix the blood and broth by rotating gently to avoid clotting.
- **Cerebrospinal fluid (CSF):**Clean the skin over L3-L4 inter-space with 70% alcohol and iodine. Collect > 1.0 ml CSF in a sterile screw-capped tube. Keep the CSF in an incubator at 35-37 degree centigrade, if it is not processed immediately.
- Exudates from joints/middle earCollect > 1.0 ml by aspiration in a sterile screw-capped tube or add directly to a culture broth used for blood culture.
Note:Â DO NOT REFRIGERATE THE SAMPLE
Sample Transport
H. influenzae is a fastidious bacteria. Care must be taken during the transport of the specimen. Specimens must be transported promptly to the laboratory preferably within 1-2 hours.
Blood can only be transported after collecting in a culture broth containing appropriate anticoagulant. The inoculated medium can be held at room temperature (20°C– 25****°C) for 4 – 6 hours before incubation at 37**°C. The samples during transportation should be protected from extremes of temperature (less than 18**°C, more than 30**°**C) and direct sunlight.
Direct Examination
- Perform Gram stain
- Gram staining shows Gram-negative pleomorphic thin rods or coccobacilli.
Culture
- Inoculate samples onto chocolate agar media (think why not blood agar or any other media)
- Incubate at 37°C in an aerobic atmosphere containing 5-10% CO2 for 24-48 hours.

Colony morphology onchocolate agar:
- large flat, colorless to gray or opaque colonies.
- Colonies are 0.5 – 1mm circular, low convex, smooth, pale grey, and transparent.
- With a characteristic “mouse nest” odor. No hemolysis or discoloration is seen.
- Encapsulated strains appear more mucoid (watery) and non-capsulated strains appear as compact greyish colonies.
Note: Â Â Growth is enhanced on chocolate agar andsatellitismaround Staphylococcus aureus is seen on blood agar.
Biochemical reactions for differentiation
Confirmatory tests for X and V factor requirements.
- Inoculate a single suspected colony from chocolate agar onto Mueller Hinton agarplates.
- Place commercially available X, V, and XV factor discs/strips on streaked plates.
- Incubate plates at 37°C in a 5-10% CO2 atmosphere for 18-24 hours.
- Observe growth around the discs and H. influenzae will only grow around the combined XV disc.
Note that if only X and V factor discs (without XV) are applied, place them at least 2 cm apart and H. influenzae will grow between the two discs.
Serological identification (serotyping) ofHaemophilus influenzae
Agglutinating antisera for serotypes “a” to “f” are available commercially. Such sera contain antibodies directed towards somatic antigens present in the patient’s sera which result in agglutination.
Slide agglutination test.****
- Apply one drop of normal saline on a slide and make a homogenous suspension with a single suspected colony of H. influenzae.
- Add one drop of specific antiserum and mix thoroughly.

Reading
- Observe for agglutination (visible clumping) within 1 minute.
Interpretation.
- A visible clumping within 1 minute is indicative of a positive reaction.
Antimicrobial susceptibility testing
- Perform antimicrobial susceptibility test against a selected group of antimicrobials by a disk-diffusion method.
- Follow the standard techniques as provided in the manual.
References
- Hirschmann, J. V., & Everett, E. D. (1979). Haemophilus influenzae infections in adults: report of nine cases and a review of the literature. Medicine, 58(1), 80–94. https://doi.org/10.1097/00005792-197901000-00005
- Agrawal, A., & Murphy, T. F. (2011). Haemophilus influenzae infections in the H. influenzae type b conjugate vaccine era. Journal of clinical microbiology, 49(11), 3728–3732. https://doi.org/10.1128/JCM.05476-11
- Bachiller Luque, P., Eiros Bouza, J. M., & Blanco QuirĂłs, A. (2000). Manifestaciones clĂnicas, diagnĂłstico y tratamiento de la infecciĂłn por Haemophilus influenzae [Clinical manifestations, diagnosis and treatment of Haemophilus influenzae infection]. Anales de medicina interna (Madrid, Spain : 1984), 17(4), 204–212.
- Bailey & Scott’s Diagnostic Microbiology, Forbes, 11th edition
- Madigan Michael T, Bender, Kelly S, Buckley, Daniel H, Sattley, W. Matthew, & Stahl, David A. (2018). Brock Biology of Microorganisms (15th Edition). Pearson.